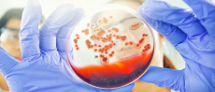
קצת על הנדסה ביו-רפואית קצת על הנדסה ביו-רפואית

ביו קוביה 7 - קצת עלינו
סוג התוכן:
קובית תוכן מותאמת אישית
כותרת פריט התוכן:
קצת עלינו
קישור:
טקסט:
בתחום של הנדסה ביו-רפואית מפתחים שיטות הנדסיות ומיישמים שיטות קיימות במחקר ביולוגי ורפואי. חלק מהמחקר הוא מחקר בסיסי שמטרתו לפתח הבנה טובה יותר של מערכות ביולוגיות. חלקו האחר של המחקר הוא יישומי שמטרתו לקדם ולשפר את הטיפול הרפואי...
תמונה:
האם להשתמש בתמונת עיגול:
תמונה מעוגלת:
טקסט על התמונה:
אירועים
כותרת להצגה:
קצת על הנדסה ביו-רפואית
שיוך לקבוצה:
